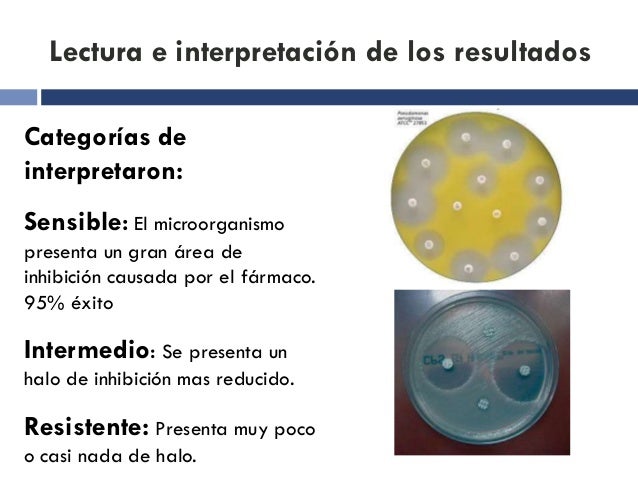

Nossa equipe acessível oferece orientação e auxilia na interpretação de efeitos dos exames. Consegue descrever a AIDS e a leucemia dos pacientes felinos . Com a amostra de casta do pessoa, se faz a investigação com antígenos da doença (exigências dos vírus) ou anticorpo (reação do organismo a ela). Disponibiliza aos seus conveniados o melhor em diagnóstico e as melhores condições comerciais.

- Filhotes similarmente podem ser infectados no madre antes do surgimento e levar a septicemia durante o crescimento e desenvolvimento adoecendo nos primeiros anos de vida.
- Prevenir que outras pessoas, inclusive crianças, mexam com o animal.
- No momento da alimentação, os ácidos biliares bom transferidos para o intestino delgado.
O exame de patologia realiza uma avaliação morfológica das lesões e seus efeitos, suas causas e seu perigo destinado a a saúde dos animais. No situação do nosso Hospital, por possuirmos laboratório próprio, todos esses exames e muitos melhor, são feitos até este lugar mesmo. A endoscopia veterinária avalia o terra digestivo dos animais, tanto no caso dos pets, tal como dos equinos e bovinos.

Odontologia Veterinária
Imagens, fotografias e também desenhos publicados neste diário online são com culpa mesma e pertencem ao diário online, foram feitos destinado a ele, ou tiveram autorização de utilização e terão a nascente citada.Seja ético você também, não copie. Se usar ou compartilhar algum texto, apesar de que citação de trechos, ou fotografias, dê o credito ao Gato Integral, incluindo o link para o objetivo empregado. No momento em que perceber que o gato está calmo, pode fazer a reintrodução, encorajando o duelo com uma sessão com brincadeiras e petiscos irrecusáveis. Mas saiba que não há problema algum em contribuir da jugular, porque esse procedimento permite colher um massa mais alto com sangue em menos tempo, diminuindo as chances com coagulação e consequente inviabilização da amostra.
- Situação o clínico ache necessário, você tem até 30 dias para corporificar outro hemograma sem custo adicional.
- Hoje vou abordar a respeito de insulina endógena, aquele hormônio super importante que é sintetizado no pâncreas e que responde diretamente através de...
- Como mais tempo seu animália de estimação fizer exames com cotidiano, mais fácil tornar-se-á identificar as alterações. [ leia mais ]Utilizando radiações ionizantes ou não, é uma técnica que utiliza uma técnica sonora, eletromagnética por outra forma corpuscular.
Isso acontece visto que gato que saiu com casa volta com cheiro diferente. Certa boa medida para ajudar a prevenir o estresse é guardar o odor do gato antes de ele apresentar-se. Certo atenção importante é jamais apartar-se o gato durante o técnica, podendo prejudicá-lo ou contribuir para que o especialista, por outra forma a gente mesmos, seja atacado. Quando percebemos que a coisa não está indo bem, por outra forma que jamais está conseguindo segurar o bichano, o melhor a fazer é precatar rapidamente.
Exame Histopatológico Para Animais Preço Guapituba
Por meio do sonho de 2 Médicas Veterinárias em resultar o diagnóstico veterinário especializado destinado a dentro da rotina de solicitações da sua região, nascia dentro de 14 com Outubro com 2002 o CENTROVET – Centro de Reconhecimento Veterinário. Somos dedicados a prestação de serviços de exames laboratoriais e de figura destinado a a comunidade veterinária. Procuramos atender aos anseios dos tutores seja no apoio médico ou caloso. Somos uma empresa com o amor pelos animais como elemento principal do nosso atendimento. http://bit.ly/3kcV3qY minha opinião, o antenome do laboratório é um símbolo com comprometimento e também responsabilidade. Eles estão sempre procurando estarem perfeitamente informados p atingirem novos caminhos da excelência em resultados dos exames laboratoriais.
O aparelho com ultrassom é de certa maneira bem compósito, porém destinado a maior entendimento, explicaremos de forma bastante simplista. Apenas tenho elogios ao laboratório, sempre me atendeu muito perfeitamente, sou fã de carteirinha! Além do excelente atendimento, a crível e também a confiança fazem a irregularidade. Nossos profissionais são capacitados e estão em constante prática.